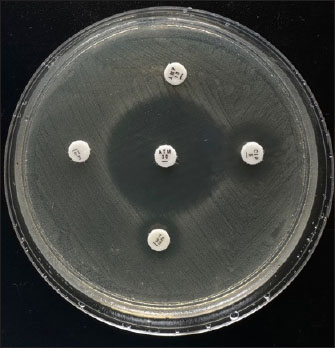

| Research Article | ||
Open Vet. J.. 2025; 15(1): 92-97 Open Veterinary Journal, (2025), Vol. 15(1): 92-97 Research Article Molecular detection of blaTEM-encoding genes in multidrug-resistant Escherichia coli from cloacal swabs of ducks in Indonesia farmsSusmitha Nur Ahadini1, Wiwiek Tyasningsih2*, Mustofa Helmi Effendi3, Aswin Rafif Khairullah4, Muhammad Khaliim Jati Kusala4, Ima Fauziah4, Latifah Latifah5, Ikechukwu Benjamin Moses6, Sheila Marty Yanestria7, Kartika Afrida Fauzia8,9, Dea Anita Ariani Kurniasih10 and Syahputra Wibowo111Master Program of Veterinary Science and Public Health, Faculty of Veterinary Medicine, Universitas Airlangga, Surabaya, Indonesia 2Division of Veterinary Microbiology, Faculty of Veterinary Medicine, Universitas Airlangga, Surabaya, Indonesia 3Division of Veterinary Public Health, Faculty of Veterinary Medicine, Universitas Airlangga, Surabaya, Indonesia 4Research Center for Veterinary Science, National Research and Innovation Agency (BRIN), Bogor, Indonesia 5Research Center for Animal Husbandry, National Research and Innovation Agency (BRIN), Bogor, Indonesia 6Department of Applied Microbiology, Faculty of Science, Ebonyi State University, Abakaliki, Nigeria 7Faculty of Veterinary Medicine, Universitas Wijaya Kusuma Surabaya, Surabaya, Indonesia 8Research Center for Preclinical and Clinical Medicine, National Research and Innovation Agency (BRIN), Bogor, Indonesia 9Department of Environmental and Preventive Medicine, Faculty of Medicine, Oita University, Yufu, Japan 10Research Center for Public Health and Nutrition, National Research and Innovation Agency (BRIN), Bogor, Indonesia 11Eijkman Research Center for Molecular Biology, National Research and Innovation Agency (BRIN), Bogor, Indonesia *Corresponding Author: Wiwiek Tyasningsih. Division of Veterinary Microbiology, Faculty of Veterinary Medicine, Universitas Airlangga, Surabaya, Indonesia. Email: wiwiek-t [at] fkh.unair.ac.id Submitted: 20/09/2024 Accepted: 02/12/2024 Published: 31/01/2025 © 2025 Open Veterinary Journal
AbstractBackground: Globally, there is an increasing frequency of community-acquired illnesses caused by extended-spectrum beta-lactamase (ESBL)-producing Escherichia coli. The presence of ESBL-producing E. coli in livestock is a concern, considering its transmission potential to humans, effects on animal health, risks to food safety, and the widespread spread of antibiotic resistance in both human and animal populations. Aim: This study investigated the prevalence and characterization of ESBL-producing E. coli in cloacal swab samples collected from duck farms in Jombang, Indonesia. Methods: In total, 125 cloacal swab samples of ducks were collected from farms. Samples were processed and analyzed for E. coli isolation using standard microbiology techniques. Isolated E. coli strains were further subjected to antimicrobial susceptibility testing and ESBL phenotypic detection using disc diffusion and double-disk synergy test techniques, respectively. Identified multidrug-resistant (MDR) E. coli strains were thereafter screened for the detection of blaTEM ESBL gene by PCR. Results: A total of 94 (52.2%) out of the collected 180 swab samples were positive for E. coli. Twenty-five (39.1%) out of the recovered E. coli isolates were generally noted to exhibit MDR traits. Exactly 24 (96%) out of the 25 MDR E. coli strains that were selected for molecular studies harbored the blaTEM gene. Conclusion: The detection of MDR E. coli harboring blaTEM ESBL gene in ducks in our study area is a significant public health problem. Therefore, strong and impactful preventive measures, which would curtail the increasing dissemination of MDR bacterial pathogens in agricultural settings, are urgently needed. Keywords: blaTEM gene, ducks, E. coli, multidrug resistance, public health, antibiotics. IntroductionThe Indonesian population is increasing every year, causing the need for food to increase. Duck, as a source of animal protein, has become a food choice for people because not only does it taste delicious but also it is quite affordable; therefore, more duck farms have emerged to meet market needs (Kuźniacka et al., 2020). There are many openings of new farms that have a positive impact on meeting people’s food needs, but livestock also have a negative impact on the form of waste, which has the potential to cause environmental pollution (Godde et al., 2021; Riwu et al., 2022). Based on data from the National Statistics Agency (CBS, 2019), the duck population in Jombang Regency in 2019 was 2,85,176, which has increased to 3,15,822 in 2020; this number is above the average number of duck populations in other cities and districts in East Java. The number of ducks in Jombang Regency continues to increase, indicating that many new farms have opened in this area, where it could be said that the duck farming business in Jombang Regency has the potential to grow even bigger. One of the livestock wastes is livestock manure. Coliform bacteria are commonly found in feces (Alegbeleye and Sant’Ana, 2020). Coliform bacteria consist of four major genera, namely Enterobacter, Klebsiella, Citrobacter, and Escherichia. Escherichia coli is one of the most commonly found groups of coliform bacteria. There are E. coli strains that are commensal, harmless, and some that are pathogenic in humans and animals (Ramos et al., 2020). E. coli in poultry can cause diseases, such as colibacillosis, omphalitis, air sacculitis, peritonitis, and salphingitis (Effendi et al., 2022a). The use of antibiotics in commercial livestock can be said to be unavoidable because the large population of livestock in a limited space makes the possibility of disease occurring in a pen greater and giving antibiotics is one of the preventive measures that is usually taken (Tyasningsih et al., 2022). Inappropriate administration of antibiotics can result in antibiotic resistance, which can be detrimental to life. Gram-negative bacteria worldwide continue to develop resistance to β-lactam antibiotics due to the widespread use of these antibiotics as the first-line treatment for bacterial illnesses (Putri et al., 2023). The persistent exposure of β-lactams to bacteria leads to continuous production of β-lactamase mutations that expand activity against even the newest β-lactam antibiotics. This enzyme is known as extended-spectrum β-lactamase (ESBL) (Wibisono et al., 2021). Resistance resulting from ESBL often coexists with resistance to various antibiotic families that are often employed in human treatment. Since ESBL-producing E. coli bacteria can be transmitted to people, they pose a risk to animal health, food safety, and the spread of antibiotic resistance in both human and animal populations (Yanestria et al., 2022). ESBL-producing bacteria in humans cause limited treatment options because the bacteria usually exhibit resistance to many classes of antibiotics. Urinary tract infection (UTI) in humans is a bacterial infection that does not have many antibiotic options for treatment because it is mostly caused by ESBL-producing E. coli (Zhou et al., 2023). Research on ESBL-producing bacteria is needed within the scope of veterinary medicine, which concerns public health. Knowing the spread of ESBL-producing bacteria in animals is necessary to develop strategies to mitigate its spread. Although there are a series of reports on the spread of ESBL-producing E. coli in livestock, especially chickens, and cattle, among others; however, studies conducted on ducks, which are also one of the major sources of animal protein in Indonesia, are scarce, hence, this study. Materials and MethodsEthical approvalEthical clearance for this study was approved by the Faculty of Veterinary Medicine, Universitas Airlangga, Indonesia’s ethical committee on the use of animals in research (Ethics no: 1.KEH.073.05.2024). Collection of samplesA total of 180 cloacal swab samples of ducks were aseptically collected in three distinct duck farms located in Jombang, East Java, Indonesia, between March 2024 and July 2024. Collected cloacal swab samples were labeled accordingly and transported to the laboratory within two hours of collection for bacteriological analysis. Bacteriological analysis of samplesCollected duck cloacal swabs were first enriched in MacConkey broth (Merck, Germany) and incubated at 37˚C for 24 hours. A loopful from the inoculated MacConkey broth was then transferred to eosine methylene blue (EMB) agar (Merck, Germany) plates and incubated at 37˚C for 24 hours. Colonies typical of E. coli (greenish-metallic sheen on EMB agar) were subcultured through successive streaking in order to obtain pure colonies, which were then subjected to Gram staining and further biochemical characterization such as IMViC (indole, methyl red, Voges–Proskauer, and citrate tests). Pure colonies of identified isolates were then preserved at 4°C for further tests. Antimicrobial susceptibility testing and phenotypic ESBL detectionThis was done by the disc diffusion method on Mueller–Hinton agar (MHA) according to the Clinical and Laboratory Standards Institute (CLSI) guidelines (CLSI, 2020). Mueller–Hinton (MH) agar (Merck, Germany) was prepared according to the manufacturer’s instructions. An 18–24-hour-old broth culture of the test isolate was standardized to 0.5 McFarland’s standard. A sterile swab stick was inserted into the standardized inoculums and inoculated by spreading on the surface of the prepared MHA plate. The inoculated MHA plate was allowed to dry for a few minutes at room temperature with the lid closed. The following antimicrobials (Oxoid, UK) were tested against the isolates: ampicillin (10 µg), erythromycin (15 µg), tetracycline (30 μg), ciprofloxacin (5 µg), and aztreonam (30 µg). All antibiotic discs were carefully placed on the inoculated MHA plates using sterile forceps. The inoculated MHA plates were then incubated at 37°C for 18–24 h. After incubation, the CLSI recommendations were followed in measuring, recording, and interpreting inhibition zone diameters as resistant or susceptible (CLSI, 2020). E. coli ATCC 25923 and Klebsiella pneumoniae ATCC 700603 were used as quality control strains. Phenotypic detection of ESBL-producing E. coli was done using the double-disk synergy test as previously described (Wibisono et al., 2021). blaTEM gene detectionAll the 25 isolated strains that were identified as MDR were further subjected to molecular characterization for blaTEM gene using PCR. First, bacterial DNA was isolated using the QIAamp® DNA Mini Kit (QIAGEN, Germany) according to the manufacturer’s protocol. The primers used in this study were blaTEM-Forward 5’-ATGAGTATTCAACATTTCCG-3’ and blaTEM-Reverse 5’-CTGACAGTTACCAATGCTTA-3’ (Ballhausen et al., 2014). The PCR reaction conditions were performed as previously described (Fouladi et al., 2011) in a thermocycler with slight modifications, which included pre-denaturation for one minute at 95°C, 40 denaturation cycles for one minute at 95°C, annealing for one minute at 55°C, and extension for one minute at 72°C. A final extension lasting two minutes at 72°C marked the end of the amplification step. Electrophoresis was run in a 2% agarose gel with SYBR® safe DNA gel stain at 100 V and 250 mA for 35 minutes. A UV transilluminator was used to view the amplified PCR products. ResultsResults showed that 94 (52.2%) out of the 180 cloacal swab samples collected from ducks in duck farms located in Jombang, East Java, Indonesia were positive for E. coli. Isolates were noted to be green metallic sheen colonies in EMB agar. They were Gram-negative and were positive for motility, indole, and methyl red tests but were negative for hydrogen sulfide production, Voges–Proskauer (VP), and citrate tests. Isolates were also observed to be resistant to aztreonam (98.9%), erythromycin (94.7%), tetracycline (57.4%), ampicillin (41.5%), and ciprofloxacin (12.8%) being the least (Table 1, Fig. 1). Twenty-five (39.1 %) out of the recovered E. coli isolates were generally noted to exhibit MDR traits. None of the E. coli strains displayed ESBL production via the double-disk synergy test (DDST); however, 24 (96%) out of the 25 MDR E. coli strains that were selected for molecular studies harbored blaTEM ESBL gene (Figs. 2 and 3). Table 1. Antimicrobial susceptibility profiles of E. coli recovered from cloacal swabs of ducks
Fig. 1. Representative picture of antimicrobial susceptibility testing of E. coli isolates. DiscussionBacterial pathogens, such as E. coli, which belongs to the Enterobacteriaceae family and harbors the extended-spectrum beta-lactamase (ESBL)-encoding genes, are one of the main contributors to the challenging public health problems in the world today (WHO, 2016). Bacteria that harbor the ESBL genes can produce ESBL enzymes, which can hydrolyze beta-lactam antibiotics, including third- and fourth-generation cephalosporins. Many of the identified ESBL gene variants, including blaTEM, blaSHV, and blaCTX-M, have been identified to be plasmid-mediated (Husna et al., 2023). In this study, 94 (52.2%) E. coli were recovered from 180 cloacal swab samples of ducks in various duck farms in Jombang, East Java, Indonesia, with only 25 being identified as exhibiting MDR strains. All the isolates were negative for the phenotypic detection of ESBL using the DDST technique; however, 24 out of the 25 MDR E. coli strains that were further molecularly characterized harbored the blaTEM gene. DDST is a simple and easy method for detecting ESBL, but DDST does not detect all ESBL-producing isolates. Additionally, the CLSI recommends a phenotypic confirmatory disk diffusion test (PCDDT) as a confirmation test for ESBL. However, we suspect that the non-detection of ESBL enzymes in the E. coli strains in this study by the DDST test might possibly be due to the production of Chromosomal cephalosporinase (Kaur et al., 2013). The results of our study have further reinforced that DDST needs to be followed up with a PCR for the genetic confirmation of ESBL-production, thus, making PCR a gold standard for ESBL detection.
Fig. 2. PCR result for blaTEM detection in E. coli isolates (1/2).
Fig. 3. PCR result for blaTEM detection in E. coli isolates (2/2). The frequency of blaTEM gene (96%) among the 25 MDR E. coli isolates that were molecularly characterized in this study is higher than the study of Sarker et al. (2023) who also reported blaTEM gene in 72.4% of duck cloacal swab samples. Inappropriate and excessive use of antibiotics cause selective pressure that favors the growth of resistant bacteria. Through conjugative plasmid-mediated horizontal gene transfer, the colonization of resistant bacteria in the intestines of people and animals results in the transmission of bacterial resistance genes in the intestinal flora. The majority of plasmid genes encode ESBLs. It was discovered that Enterobacteriaceae possessed plasmids containing resistance genes. The blaTEM gene is located on a plasmid (Gulfraz et al., 2014). The IncFII plasmid group is known to be a group that encodes ESBL, is widely distributed in Enterobacteriaceae, and is called the epidemic resistance plasmid group. blaTEM is one of the dominant ESBL genes in the world and is found in human, animal, and environmental isolates. The blaTEM gene was found mainly in E. coli and Klebsiella pneumoniae bacterial isolates (Soekoyo et al., 2020). The blaTEM gene is a beta-lactamase most often found in Gram-negative bacteria. Most ampicillin resistance in E. coli is caused by the presence of the blaTEM gene (Effendi et al., 2022b). The existence of resistant bacteria in food-producing animals is caused by the continuous use of antibiotics for therapeutic and non-therapeutic purposes in production systems, which may be found in products of animal origin. It is known that the main mechanism by which microbial populations can survive in threatened situations is through genetic mutation, expression of a latent resistance gene, or genes that have resistance determinants. Some bacteria have extrachromosomal genes in the form of plasmids or bacteriophages. The resistance factor that is transferred from a chromosome to a plasmid or on a transposon or integron is an R factor plasmid, which is called an infectious plasmid. This transfer can occur through conjugation, transformation, or transduction. Transposons containing resistance genes carry out inversion into plasmids so that resistance genes can be transferred to other cells (Partridge et al., 2018). The blaTEM resistance gene harbored by the E. coli strains in this study may be plasmid-mediated or chromosomal-mediated. However, a limitation of our study was our inability to carry out further test to determine the location of the blaTEM resistance gene in the recovered E. coli isolates from duck cloacal swabs. In a study conducted by Oberoi et al. (2013), 96 (35.16%) ESBL-producing Gram-negative bacterial pathogens were also reported, out of which 45.9% were implicated as culprits in UTIs. Additionally, the largest ESBL producers in the study of Oberoi et al. (2013) were Escherichia coli (56.25%), Pseudomonas aeruginosa (18.75%), and Klebsiella pneumoniae (15.62%). Infections caused by MDR Gram-negative bacteria, which produce various types of β-lactamase enzymes, affect the length of stay in the ICU, as they are associated with patient morbidity and mortality. Many β-lactamases are encoded by chromosomal or transferable genes, located on plasmids or transposons. Initially, the β-lactamase enzyme was most often found in Klebsiella sp. and E. coli, but now, this enzyme is produced by all members of the Enterobacteriaceae and other Gram-negative bacilli (Al-Sheboul et al., 2023). blaTEM is one of the common beta-lactamase genes found in ESBL-producing Escherichia coli. It was one of the earliest beta-lactamase genes identified and is widely distributed among Enterobacteriaceae, including E. coli. The presence of E. coli encoding ESBL genes in poultry, including ducks, has been documented globally, including in Southeast Asia where poultry farming is prevalent. ConclusionOur study has shown that ducks, which are important sources of animal protein in East Java, Indonesia, are colonized by MDR E. coli, which also harbors blaTEM ESBL gene. The detection of these pathogenic MDR E. coli strains in duck farms in our study area is a significant public health problem, which requires urgent attention. It is therefore imperative to establish strong guidelines and control measures, which would curtail the increasing spread of MDR bacterial pathogens in agricultural settings, especially in duck farms. AcknowledgmentsThis study was done to fulfill the requirements for the degree in Masters of Science in Veterinary Disease and Veterinary Public Health, Faculty of Veterinary Medicine, Universitas Airlangga, Indonesia. Conflict of interestThe authors declare that there is no conflict of interest. FundingThis study was partly supported by the International Research Consortium, Lembaga Penelitian dan Pengabdian Masyarakat, Universitas Airlangga, Surabaya, Indonesia Year 2024 with grant number: 171/UN3.LPPM/PT.01.03/2024. Author’s contributionsSNA and WT: Conceptualization and design. IF, LL, and MKJK: Acquisition of data. MHE and IBM: Formal analysis and interpretation of data. ARK and KAF: Writing-original draft preparation. SMY, DAAK, and SW: Writing-review and editing. All authors have read and agreed to the published version of the manuscript. Data availabilityAll data are available in the manuscript. ReferencesAl-Sheboul, S.A., Al-Madi, G.S., Brown, B. and Hayajneh, W.A. 2023. Prevalence of extended-spectrum β-lactamases in multidrug-resistant klebsiella pneumoniae isolates in Jordanian Hospitals. J. Epidemiol. Glob. Health 13(2), 180–190. Alegbeleye, O.O. and Sant’Ana, A.S. 2020. Manure-borne pathogens as an important source of water contamination: an update on the dynamics of pathogen survival/transport as well as practical risk mitigation strategies. Int. J. Hyg. Environ. Health 227(1), 113524. Ballhausen, B., Kriegeskorte, A., Schleimer, N., Peters, G. and Becker, K. 2014. The mecA homolog mecC confers resistance against β-lactams in Staphylococcus aureus irrespective of the genetic strain background. Antimicrob. Agents Chemother. 58(7), 3791–3798. CBS (Central Bureau of Statistics). 2019. Duck population by district (head), 2019. Central Bureau of Statistics of Jombang Regency, East Java Province, Indonesia CLSI (Clinical and Laboratory Standards Institute). 2020. Performance standards for antimicrobial susceptibility testing. 30th ed. CLSI supplement M100. Wayne, PA: Clinical and Laboratory Standards Institute. Effendi, M.H., Hartadi, E.B., Witaningrum, A.M., Permatasari, D.A. and Ugbo, E.N. 2022a. Molecular identification of blaTEM gene of extended-spectrum beta-lactamase-producing Escherichia coli from healthy pigs in Malang district, East Java, Indonesia. J. Adv. Vet. Anim. Res. 9(3), 447–452. Effendi, M.H., Faridah, H.D., Wibisono, F.M., Wibisono, F.J., Nisa, N., Fatimah, F. and Ugbo, E.N. 2022b. Detection of virulence factor encoding genes on Escherichia coli isolated from broiler chicken in Blitar District, Indonesia. Biodiversitas 23(7), 3437–3442. Fouladi, I., Choopani, A. and Mehrabadi, F. 2011. Study of prevalence of Enterotoxin type B gene in meticillin resistant Staphylococcus aureus (MRSA) isolated from wound. Kowsar Med. J. 16(1), 21–25. Godde, C.M., Mason-D’Croz, D., Mayberry, D.E., Thornton, P.K. and Herrero, M. 2021. Impacts of climate change on the livestock food supply chain; a review of the evidence. Glob. Food Sec. 28(1), 100488. Gulfraz, M., Imran, M., Khadam, S., Ahmed, D., Asad, M.J., Abassi, K.S., Irfan, M. and Mehmood, S. 2014. A comparative study of antimicrobial and antioxidant activities of garlic (Allium sativum L.) extracts in various localities of Pakistan. Afr. J. Plant Sci. 8(6), 298–306. Husna, A., Rahman, M.M., Badruzzaman, A.T.M., Sikder, M.H., Islam, M.R., Rahman, M.T., Alam, J. and Ashour, H.M. 2023. Extended-spectrum β-Lactamases (ESBL): challenges and opportunities. Biomedicines 11(11), 2937. Kaur, J., Chopra, S., Sheevani and Mahajan G. 2013. Modified double disc synergy test to detect ESBL production in urinary isolates of Escherichia coli and Klebsiella pneumoniae. J. Clin. Diagn. Res. 7(2), 229–233. Kuźniacka, J., Biesek, J., Banaszak, M., Rutkowski, A., Kaczmarek, S., Adamski, M. and Hejdysz, M. 2020. Effect of dietary protein sources substituting soybean meal on growth performance and meat quality in ducks. Animals 10(1), 133. Oberoi, L., Singh, N., Sharma, P. and Aggarwal, A. 2013. ESBL, MBL and Ampc β lactamases producing superbugs—havoc in the intensive care units of Punjab India. J. Clin. Diagn. Res. 7(1), 70–73. Partridge, S.R., Kwong, S.M., Firth, N. and Jensen, S.O. 2018. Mobile genetic elements associated with antimicrobial resistance. Clin. Microbiol. Rev. 31(4), e00088–17. Putri, M.F.R., Kendek, I.A., Wibisono, F.J., Effendi, M.H., Rahardjo, D., Tyasningsih, W. and Ugbo, E.N. 2023. Molecular detection of iron gene on multidrug resistant avian fecal Escherichia coli isolated from broiler on traditional markets, Surabaya, Indonesia. Biodiversitas 24(12), 6454–6460. Ramos, S., Silva, V., Dapkevicius, M.L.E., Caniça, M., Tejedor-Junco, M.T., Igrejas, G. and Poeta, P. 2020. Escherichia coli as commensal and pathogenic bacteria among food-producing animals: health implications of extended spectrum β-lactamase (ESBL) Production. Animals (Basel) 10(12), 2239. Riwu, K.H.P., Effendi, M.H., Rantam, F.A., Khairullah, A.R. and Widodo, A. 2022. A review: Virulence factors of Klebsiella pneumonia as emerging infection on the food chain. Vet. World. 15(9), 2172–2179. Sarker, S., Kabir, E., Mahua, F.A., Ahmed, A., Ripon, R.K., Silva, V., Poeta, P. and Ahad, A. 2023. Antibiotic-resistant Escherichia coli isolated from duck cloacal and tap water samples at live bird markets in Bangladesh. Poult. Sci. J. 11(1), 19–27. Soekoyo, A.R., Sulistiawati, S., Setyorini, W. and Kuntaman, K. 2020. The epidemiological pattern and risk factor of ESBL (extended spectrum β-Lactamase) producing enterobacteriaceae in gut bacteria flora of dairy cows and people surronding in rural area, Indonesia. Indones. J. Trop. Infect. Dis. 8(3), 144–151. Tyasningsih, W., Ramandinianto, S.C., Ansharieta, R., Witaningrum, A.M., Permatasari, D.A., Wardhana, D.K., Effendi, M.H. and Ugbo, E.N. 2022. Prevalence and antibiotic resistance of Staphylococcus aureus and Escherichia coli isolated from raw milk in East Java, Indonesia. Vet. World 15(8), 2021–2028. WHO (World Health Organization). 2016. Critically important antimicrobials for human medicine. Geneva, Switerzland: World Health Organization. Wibisono, F.J., Sumiarto, B., Untari, T., Effendi, M.H., Permatasari, D.A. and Witaningrum, A.M. 2021. Molecular identification of ctx gene of extended spectrum beta-lactamases (ESBL) producing Escherichia coli on layer chicken in Blitar, Indonesia. J. Anim. Plant Sci. 31(4), 954–959. Yanestria, S.M., Dameanti, F.N.A.E.P., Musayannah, B.G., Pratama, J.W.A., Witaningrum, A.M., Effendi, M.H. and Ugbo, E.N. 2022. Antibiotic resistance pattern of extended-spectrum β-lactamase (ESBL) producing Escherichia coli isolated from broiler farm environment in Pasuruan district, Indonesia. Biodiversitas 23(9), 4460–4465. Zhou, Y., Zhou, Z., Zheng, L., Gong, Z., Li, Y., Jin, Y., Huang, Y. and Chi, M. 2023. Urinary Tract infections caused by uropathogenic Escherichia coli: mechanisms of infection and treatment options. Int. J. Mol. Sci. 24(13), 10537. | ||
| How to Cite this Article |
| Pubmed Style Ahadini SN, Tyasningsih W, Effendi MH, Khairullah AR, Kusala MKJ, Fauziah I, Latifah L, Moses IB, Yanestria SM, Fauzia KA, Kurniasih DAA, Wibowo S. Molecular detection of blaTEM-encoding genes in multidrug-resistant Escherichia coli from cloacal swabs of ducks in Indonesia farms. Open Vet. J.. 2025; 15(1): 92-97. doi:10.5455/OVJ.2025.v15.i1.8 Web Style Ahadini SN, Tyasningsih W, Effendi MH, Khairullah AR, Kusala MKJ, Fauziah I, Latifah L, Moses IB, Yanestria SM, Fauzia KA, Kurniasih DAA, Wibowo S. Molecular detection of blaTEM-encoding genes in multidrug-resistant Escherichia coli from cloacal swabs of ducks in Indonesia farms. https://www.openveterinaryjournal.com/?mno=221281 [Access: January 25, 2026]. doi:10.5455/OVJ.2025.v15.i1.8 AMA (American Medical Association) Style Ahadini SN, Tyasningsih W, Effendi MH, Khairullah AR, Kusala MKJ, Fauziah I, Latifah L, Moses IB, Yanestria SM, Fauzia KA, Kurniasih DAA, Wibowo S. Molecular detection of blaTEM-encoding genes in multidrug-resistant Escherichia coli from cloacal swabs of ducks in Indonesia farms. Open Vet. J.. 2025; 15(1): 92-97. doi:10.5455/OVJ.2025.v15.i1.8 Vancouver/ICMJE Style Ahadini SN, Tyasningsih W, Effendi MH, Khairullah AR, Kusala MKJ, Fauziah I, Latifah L, Moses IB, Yanestria SM, Fauzia KA, Kurniasih DAA, Wibowo S. Molecular detection of blaTEM-encoding genes in multidrug-resistant Escherichia coli from cloacal swabs of ducks in Indonesia farms. Open Vet. J.. (2025), [cited January 25, 2026]; 15(1): 92-97. doi:10.5455/OVJ.2025.v15.i1.8 Harvard Style Ahadini, S. N., Tyasningsih, . W., Effendi, . M. H., Khairullah, . A. R., Kusala, . M. K. J., Fauziah, . I., Latifah, . L., Moses, . I. B., Yanestria, . S. M., Fauzia, . K. A., Kurniasih, . D. A. A. & Wibowo, . S. (2025) Molecular detection of blaTEM-encoding genes in multidrug-resistant Escherichia coli from cloacal swabs of ducks in Indonesia farms. Open Vet. J., 15 (1), 92-97. doi:10.5455/OVJ.2025.v15.i1.8 Turabian Style Ahadini, Susmitha Nur, Wiwiek Tyasningsih, Mustofa Helmi Effendi, Aswin Rafif Khairullah, Muhammad Khaliim Jati Kusala, Ima Fauziah, Latifah Latifah, Ikechukwu Benjamin Moses, Sheila Marty Yanestria, Kartika Afrida Fauzia, Dea Anita Ariani Kurniasih, and Syahputra Wibowo. 2025. Molecular detection of blaTEM-encoding genes in multidrug-resistant Escherichia coli from cloacal swabs of ducks in Indonesia farms. Open Veterinary Journal, 15 (1), 92-97. doi:10.5455/OVJ.2025.v15.i1.8 Chicago Style Ahadini, Susmitha Nur, Wiwiek Tyasningsih, Mustofa Helmi Effendi, Aswin Rafif Khairullah, Muhammad Khaliim Jati Kusala, Ima Fauziah, Latifah Latifah, Ikechukwu Benjamin Moses, Sheila Marty Yanestria, Kartika Afrida Fauzia, Dea Anita Ariani Kurniasih, and Syahputra Wibowo. "Molecular detection of blaTEM-encoding genes in multidrug-resistant Escherichia coli from cloacal swabs of ducks in Indonesia farms." Open Veterinary Journal 15 (2025), 92-97. doi:10.5455/OVJ.2025.v15.i1.8 MLA (The Modern Language Association) Style Ahadini, Susmitha Nur, Wiwiek Tyasningsih, Mustofa Helmi Effendi, Aswin Rafif Khairullah, Muhammad Khaliim Jati Kusala, Ima Fauziah, Latifah Latifah, Ikechukwu Benjamin Moses, Sheila Marty Yanestria, Kartika Afrida Fauzia, Dea Anita Ariani Kurniasih, and Syahputra Wibowo. "Molecular detection of blaTEM-encoding genes in multidrug-resistant Escherichia coli from cloacal swabs of ducks in Indonesia farms." Open Veterinary Journal 15.1 (2025), 92-97. Print. doi:10.5455/OVJ.2025.v15.i1.8 APA (American Psychological Association) Style Ahadini, S. N., Tyasningsih, . W., Effendi, . M. H., Khairullah, . A. R., Kusala, . M. K. J., Fauziah, . I., Latifah, . L., Moses, . I. B., Yanestria, . S. M., Fauzia, . K. A., Kurniasih, . D. A. A. & Wibowo, . S. (2025) Molecular detection of blaTEM-encoding genes in multidrug-resistant Escherichia coli from cloacal swabs of ducks in Indonesia farms. Open Veterinary Journal, 15 (1), 92-97. doi:10.5455/OVJ.2025.v15.i1.8 |